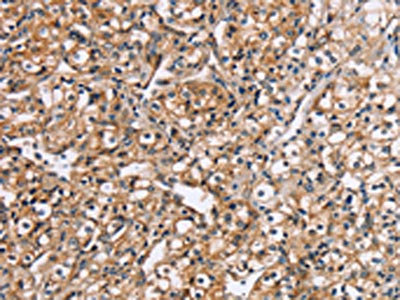

RGS1 Antibody
-
中文名稱:RGS1兔多克隆抗體
-
貨號:CSB-PA576683
-
規(guī)格:¥1100
-
圖片:
-
其他:
產(chǎn)品詳情
-
Uniprot No.:
-
基因名:RGS1
-
別名:1R20 antibody; B cell activation protein BL34 antibody; B-cell activation protein BL34 antibody; BL34 antibody; Early response protein 1R20 antibody; IER 1 antibody; IER1 antibody; Immediate early response 1 B cell specific antibody; immediate-early response 1, B-cell specific antibody; IR20 antibody; Regulator of G protein signalling 1 antibody; Regulator of G-protein signaling 1 antibody; RGS 1 antibody; RGS1 antibody; RGS1_HUMAN antibody
-
宿主:Rabbit
-
反應(yīng)種屬:Human,Mouse
-
免疫原:Fusion protein of Human RGS1
-
免疫原種屬:Homo sapiens (Human)
-
標(biāo)記方式:Non-conjugated
-
抗體亞型:IgG
-
純化方式:Antigen affinity purification
-
濃度:It differs from different batches. Please contact us to confirm it.
-
保存緩沖液:-20°C, pH7.4 PBS, 0.05% NaN3, 40% Glycerol
-
產(chǎn)品提供形式:Liquid
-
應(yīng)用范圍:ELISA,IHC
-
推薦稀釋比:
Application Recommended Dilution ELISA 1:2000-1:5000 IHC 1:25-1:100 -
Protocols:
-
儲存條件:Upon receipt, store at -20°C or -80°C. Avoid repeated freeze.
-
貨期:Basically, we can dispatch the products out in 1-3 working days after receiving your orders. Delivery time maybe differs from different purchasing way or location, please kindly consult your local distributors for specific delivery time.
-
用途:For Research Use Only. Not for use in diagnostic or therapeutic procedures.
相關(guān)產(chǎn)品
靶點(diǎn)詳情
-
功能:Regulates G protein-coupled receptor signaling cascades, including signaling downstream of the N-formylpeptide chemoattractant receptors and leukotriene receptors. Inhibits B cell chemotaxis toward CXCL12. Inhibits signal transduction by increasing the GTPase activity of G protein alpha subunits thereby driving them into their inactive GDP-bound form.
-
基因功能參考文獻(xiàn):
- Results showed that RGS1 expression was significantly higher in melanoma than that noted in nevus tissue and correlated with reduced diseasespecific survival. Also, RGS1 expression was also found to be related to the proliferation and migration of melanoma cells through regulation of Galphasmediated inactivation of AKT and ERK. PMID: 29620236
- The rs12022418 in RGS1 showed novel associations in IgA nephropathy. PMID: 27804980
- High RGS1 immunohistochemistry expression associates with poor overall survival in diffuse large B cell lymphoma PMID: 27775850
- RGS1 expression may be a prognostic marker for risk stratification and a promising target for the development of a new multiple myeloma therapy. PMID: 27445341
- Regulator of G-protein signaling 1 rs2816316 was negatively associated with celiac disease . PMID: 27043536
- RGS1 as a potential marker of CRC tissue quality PMID: 26222051
- RGS1 suppresses CXCL12-mediated migration and AKT activation in cultured human plasmacytoma cells and plasmablasts. PMID: 25897806
- Rgs1 has a role in leukocyte trafficking and vascular inflammation PMID: 25782711
- RGS1 and TNFRSF1A polymorphisms tended to be associated with reduced attack severity in Multiple sclerosis. PMID: 24130709
- RGS1 is largely upregulated, whereas RGS2 is downregulated in the majority of solid tumors, whereas RGS5 transcripts are greatly increased in eight subtypes of lymphoma with no reports of downregulation in hematological malignancies PMID: 23464602
- Markers in the RGS1 gene might be in linkage disequilibrium with a protective allele that reduces the risk of anxiety and depressive disorders. PMID: 23324853
- Elevated RGS1 levels profoundly reduce T cell migration to lymphoid-homing chemokines PMID: 21795595
- RGS1 is a novel multiple sclerosis susceptibility loci, shared with celieac disease. PMID: 20555355
- Overexpression of RGS1 in progenitor pro-B cells (which have little endogenous RGS1) impairs CXCL12-induced focal adhesion kinase activation, chemotaxis, and adhesion to membrane domains. PMID: 15728464
- RGS1 and RGS13 act together to regulate chemokine receptor signaling in human germinal center B lymphocytes and contribute significantly to the rapid desensitization of the signaling pathway. PMID: 16565322
- RGS1 is (over-) expressed in a broad variety of malignancies PMID: 18301890
- Results validate the role of RGS1 as a novel prognostic marker for melanoma given its impact on the survival associated with melanoma. PMID: 18580492
- Undifferentiated spondylarthritis (uSpA) peripheral blood mononuclear cells (PBMCs) carry more expressed genes than PBMCs from ankylosing spondylitis (AS) patients. TNFalpha- and IL-17-inducible RGS1 is a biomarker for uSpA, and to a lesser extent for AS. PMID: 19877080
顯示更多
收起更多
-
亞細(xì)胞定位:Cell membrane; Peripheral membrane protein; Cytoplasmic side. Cytoplasm, cytosol.
-
組織特異性:Detected in peripheral blood monocytes. Expression is relatively low in B-cells and chronic lymphocytic leukemia B-cells; however, in other types of malignant B-cell such as non-Hodgkin lymphoma and hairy cell leukemia, expression is constitutively high.
-
數(shù)據(jù)庫鏈接:
Most popular with customers
-
-
YWHAB Recombinant Monoclonal Antibody
Applications: ELISA, WB, IHC, IF, FC
Species Reactivity: Human, Mouse, Rat
-
-
-
-
-
-